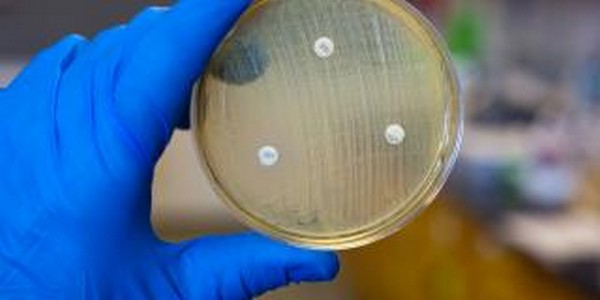
ماجستير في العلوم في التكنولوجيا الحيوية الميكروبية عن طريق البحث

الرئسية
>
الجامعات
>
جامعة بوترا الماليزية (UPM)
>
ماجستير في التكنولوجيا الحيوية الميكروبية – نظام البحث
التكلفة
13473 USD
السعر المعروض هو سعر البرنامج كاملا
نظرة عامة
المستوى
ماجستير
المدة
1-3 سنه
الفصول
سبتمبر, فبراير
اللغة
الإنجليزية
نوع الجامعة
حكومية
الموقع
ولاية سلاغور
عن التخصص
التكنولوجيا الحيوية الميكروبية هى استغلال الكائنات الدقيقة باستخدام أساليب التكنولوجيا الحيوية متعددة التخصصات لمختلف التطبيقات البيولوجية والصناعية. وتتميز الخصائص البيوكيميائية والفسيولوجية المعينة من الكائنات الدقيقة باستخدام تقنيات أو أنظمة البيولوجيا الاصطناعية لتحويلها إلى مصانع الخلية لإنتاج جزيئات مفيدة.
شاهد أيضا
 5068 USD
5068 USD
1279
المستوى
دكتوراه
المدة
2-5 سنه
الفصول
سبتمبر, فبراير
اللغة
الإنجليزية
 8050 USD
8050 USD
1189
المستوى
بكالوريوس
المدة
3.5 سنه
الفصول
سبتمبر, فبراير
اللغة
الإنجليزية
 2921 USD
2921 USD
1047
المستوى
بكالوريوس
المدة
4 سنوات
الفصول
سبتمبر, فبراير
اللغة
الإنجليزية
 4090 USD
4090 USD
1044
المستوى
بكالوريوس
المدة
4 سنوات
الفصول
سبتمبر
اللغة
الإنجليزية

